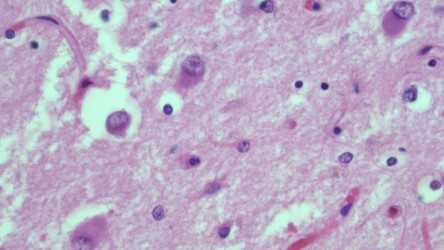
Maveal_Case_1_2022.jpg

Case History
Neuro autopsy: 50 year old male, arrived to in asystole ER and pronounced dead after rounds of ACLS protocol. Toxicology screen negative, no medical or family history, and described by local shelter as “odd , rude, and never says anything”.
What immunohistochemical or special stain would be most useful in the diagnosis?
A. Silver stain
B. Tau
C. Alpha synuclein
D. Amyloid-B
E. PrP (prion protein)
F. IDH-1 R132H

Explanation: A) tau is the most appropriate stain.
This is Frontal Temporal Lobar Degeneration (FTLD) with Pick Bodies aka Pick’s Disease. This relatively rare tauopathy ~50-100x less common than AD is clinically characterized by language impairment, progressive dementia, personality changes, and frontal disinhibition. Imaging/gross findings show frontal temporal atrophy and are described as “knifeblade” in appearance. Neurons with swollen eosinophilic cytoplasm (pick cells) are often seen, but are not necessarily specific to the disease (balloon cells are seen in other entities). Round, slightly more basophilic than the cytoplasm, cytoplasmic inclusions of predominately 3R isoform tau are Pick bodies and are found in the granule neurons of the dentate fascia and pyramidal neuros of the hippocampus.
Case contributed by: Brandon Maveal, M.D., Neuropathology Fellow, UAB Pathology